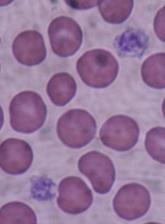

Video



For many hospitalists, mentoring is paramount in maintaining job satisfaction and sustainability
An unusual presentation highlighted the unique health maintenance challenges of reservist patients and the importance of a thorough history for...
The SYK inhibitor fostamatinib did not meet the primary endpoint in a phase 3 study of adults with chronic/persistent immune thrombocytopenia (ITP...

LEIPZIG, GERMANY—Combination therapies including the investigational drug MOR202 have produced “encouraging and long-lasting responses” in a phase...

to receive radiation Photo by Rhoda Baer The US Food and Drug Administration (FDA) has warned healthcare providers to stop using radiation...

Although pediatric hospitalizations are driven mostly by medical problems, comorbid psychiatric problems are increasingly adding to the cost.

The low-income subsidy in Medicare Part D is helping to eliminate racial disparities in adherence to hormonal therapy among breast cancer patients...

The Texas Medical Board (TMB) has dropped an appeal that had challenged whether national telemedicine company Teladoc could sue over telemedicine...